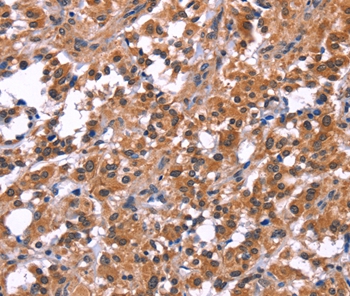

PIP5K1B Antibody - N-terminal region (OAAB17396)
OAAB17396
ApplicationsWestern Blot, ImmunoHistoChemistry
Product group Antibodies
TargetPIP5K1B
Overview
- SupplierAviva Systems Biology
- Product NamePIP5K1B Antibody - N-terminal region (OAAB17396)
- Delivery Days Customer23
- ApplicationsWestern Blot, ImmunoHistoChemistry
- CertificationResearch Use Only
- ClonalityPolyclonal
- Concentration0.5 mg/ml
- FormatPurified polyclonal antibody supplied in PBS with 0.09% (W/V) sodium azide. This antibody is prepared by Saturated Ammonium Sulfate (SAS) precipitation followed by dialysis against PBS.
- Gene ID8395
- Target namePIP5K1B
- Target descriptionphosphatidylinositol-4-phosphate 5-kinase type 1 beta
- Target synonymsMSS4; phosphatidylinositol 4-phosphate 5-kinase type I beta; phosphatidylinositol 4-phosphate 5-kinase type-1 beta; PIP5K1-beta; PIP5KIbeta; protein STM-7; ptdIns(4)P-5-kinase 1 beta; STM7; type I phosphatidylinositol 4-phosphate 5-kinase beta
- HostRabbit
- Storage Instruction2°C to 8°C,-20°C
- UNSPSC12352203